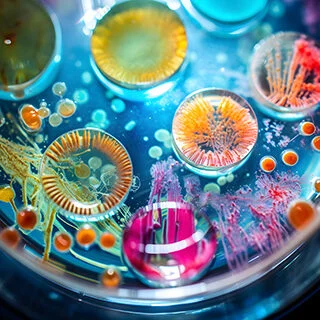
320x320 placeholder

Accelerating
Biomedical Innovation
Driving breakthrough discoveries for better healthcare outcomes.

What We Do
The Science Philanthropy Accelerator for Research and Collaboration (SPARC) at Milken Institute Strategic Philanthropy leads high-impact initiatives that accelerate biomedical research and turn innovation into real-world health improvements. We invest in tools, treatments, and technologies that fast-track progress.
Our team of scientists and philanthropy experts partners with passionate funders to navigate the complex biomedical landscape. Through strategic, science-driven initiatives, we drive lasting change in human health and bring breakthrough discoveries closer to the people who need them most.
Impact
Focus Areas
SPARC’s initiatives drive innovation across the biomedical ecosystem—advancing research, accelerating therapeutics, and transforming clinical care to improve health outcomes for millions. Our work spans a wide range of focus areas in biomedical research, health care, and the broader scientific ecosystem, including:
Team Member Highlights
Updates & Insights
Keep up with SPARC’s ongoing projects, expert insights, guides for smarter giving, and more.

The Value of Collaboration in Rare Disease Research
Childhood brain cancers are among the rarest and most difficult to treat, but new models of collaboration are changing what’s possible. This article explores how philanthropy, advocacy, and cross-sector partnerships are breaking down barriers and accelerating progress toward better treatments.

The Power of Community for Rare Disease Research
Collaboration and community are vital in tackling rare diseases like sarcoidosis. This piece highlights how new initiatives are connecting researchers, patients, and funders to drive progress.

Strategic Philanthropy Can Bridge a Rare Disease that Causes Blindness with Common Neurodegenerative Disorders
LHON causes sudden, irreversible blindness. SPARC’s partnership with the LHON Collective and the Giving Smarter Guide highlights how philanthropy can accelerate research, foster collaboration, and drive progress toward treatments that restore vision and improve lives.

Meeting the Need for Equitable and Inclusive Biomedical Research Around the Globe
Precision medicine is transforming health care, but uneven representation in genetic research limits its reach and equity. This session explores how global collaboration, inclusive infrastructure, and philanthropic investment can ensure that precision medicine benefits all populations.